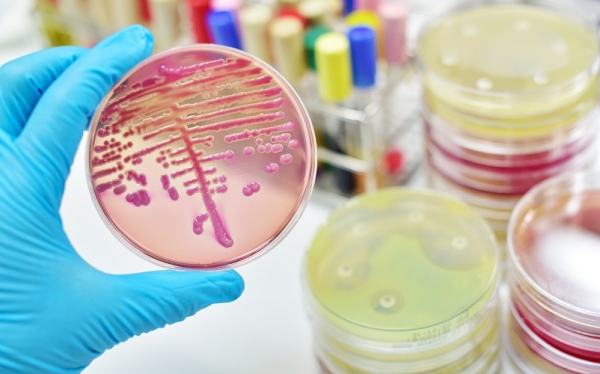

Vários dados relacionados Bactérias Gram Positivas E Gram Negativas Exemplos.
Cocos Gram Positivos

Fonte de : pt.slideshare.net
Bacteria Gram Negativa Wikipedia A Enciclopedia Livre

Fonte de : pt.wikipedia.org
Ppt Bacilos Gram Negativos Identificacao Laboratorial Powerpoint

Fonte de : www.slideserve.com
Pesquisa De Bacilos Gram Negativos Nao Fermentadores No Interior

Fonte de : www.rbac.org.br
Http Www Unirio Br Dmp Microbiologia Nutricao Integral Aulas Teoricas 3 20caracteristicas 20gerais 20das 20bacterias 20 Citologia 2001 2017 Pdf

Fonte de :
Bacteria Gram Positiva

Fonte de :
Diferencas Entre Bacterias Gram E Gram Bio Nota 10

Fonte de : virginiasamor.blogspot.com

Aqui está a informação completa sobre bactérias gram positivas e gram negativas exemplos. O administrador do blog de Novo Exemplo 01 January 2019 também coleta outras imagens relacionadas ao bactérias gram positivas e gram negativas exemplos abaixo.
Tratamento De Sepsis Provocada Por Bacterias Gram Negativas Pyrostar

Fonte de : www.wakopyrostar.com
Vetores De Estrutura Da Parede Celular De Bacterias Grampositivas

Fonte de : www.istockphoto.com
Tecnica De Gram Wikipedia A Enciclopedia Livre

Fonte de : pt.wikipedia.org
Antibioticos Importancia Terapeutica E Perspectivas Para A

Fonte de : dx.doi.org
Questionario Bacterias Cbs06051 Ufrgs Studocu

Fonte de : www.studocu.com
Added By Radionizante Instagram Post Diferenca Entre Bacteria

Fonte de : www.picuki.com
Hematoxilina Eosina E Outras Coloracoes Histologicas E Microbianas

Fonte de : blog.jaleko.com.br
Chemical Composition And Antioxidant And Antibacterial Activities

Fonte de : www.scielo.br
Antimicrobial Susceptibility Of The Uropathogens In Out Patients

Fonte de : www.scielo.br
Essa é a discussão que podemos fornecer sobre bactérias gram positivas e gram negativas exemplos. Obrigado por visitar o blog Novo Exemplo 01 January 2019.